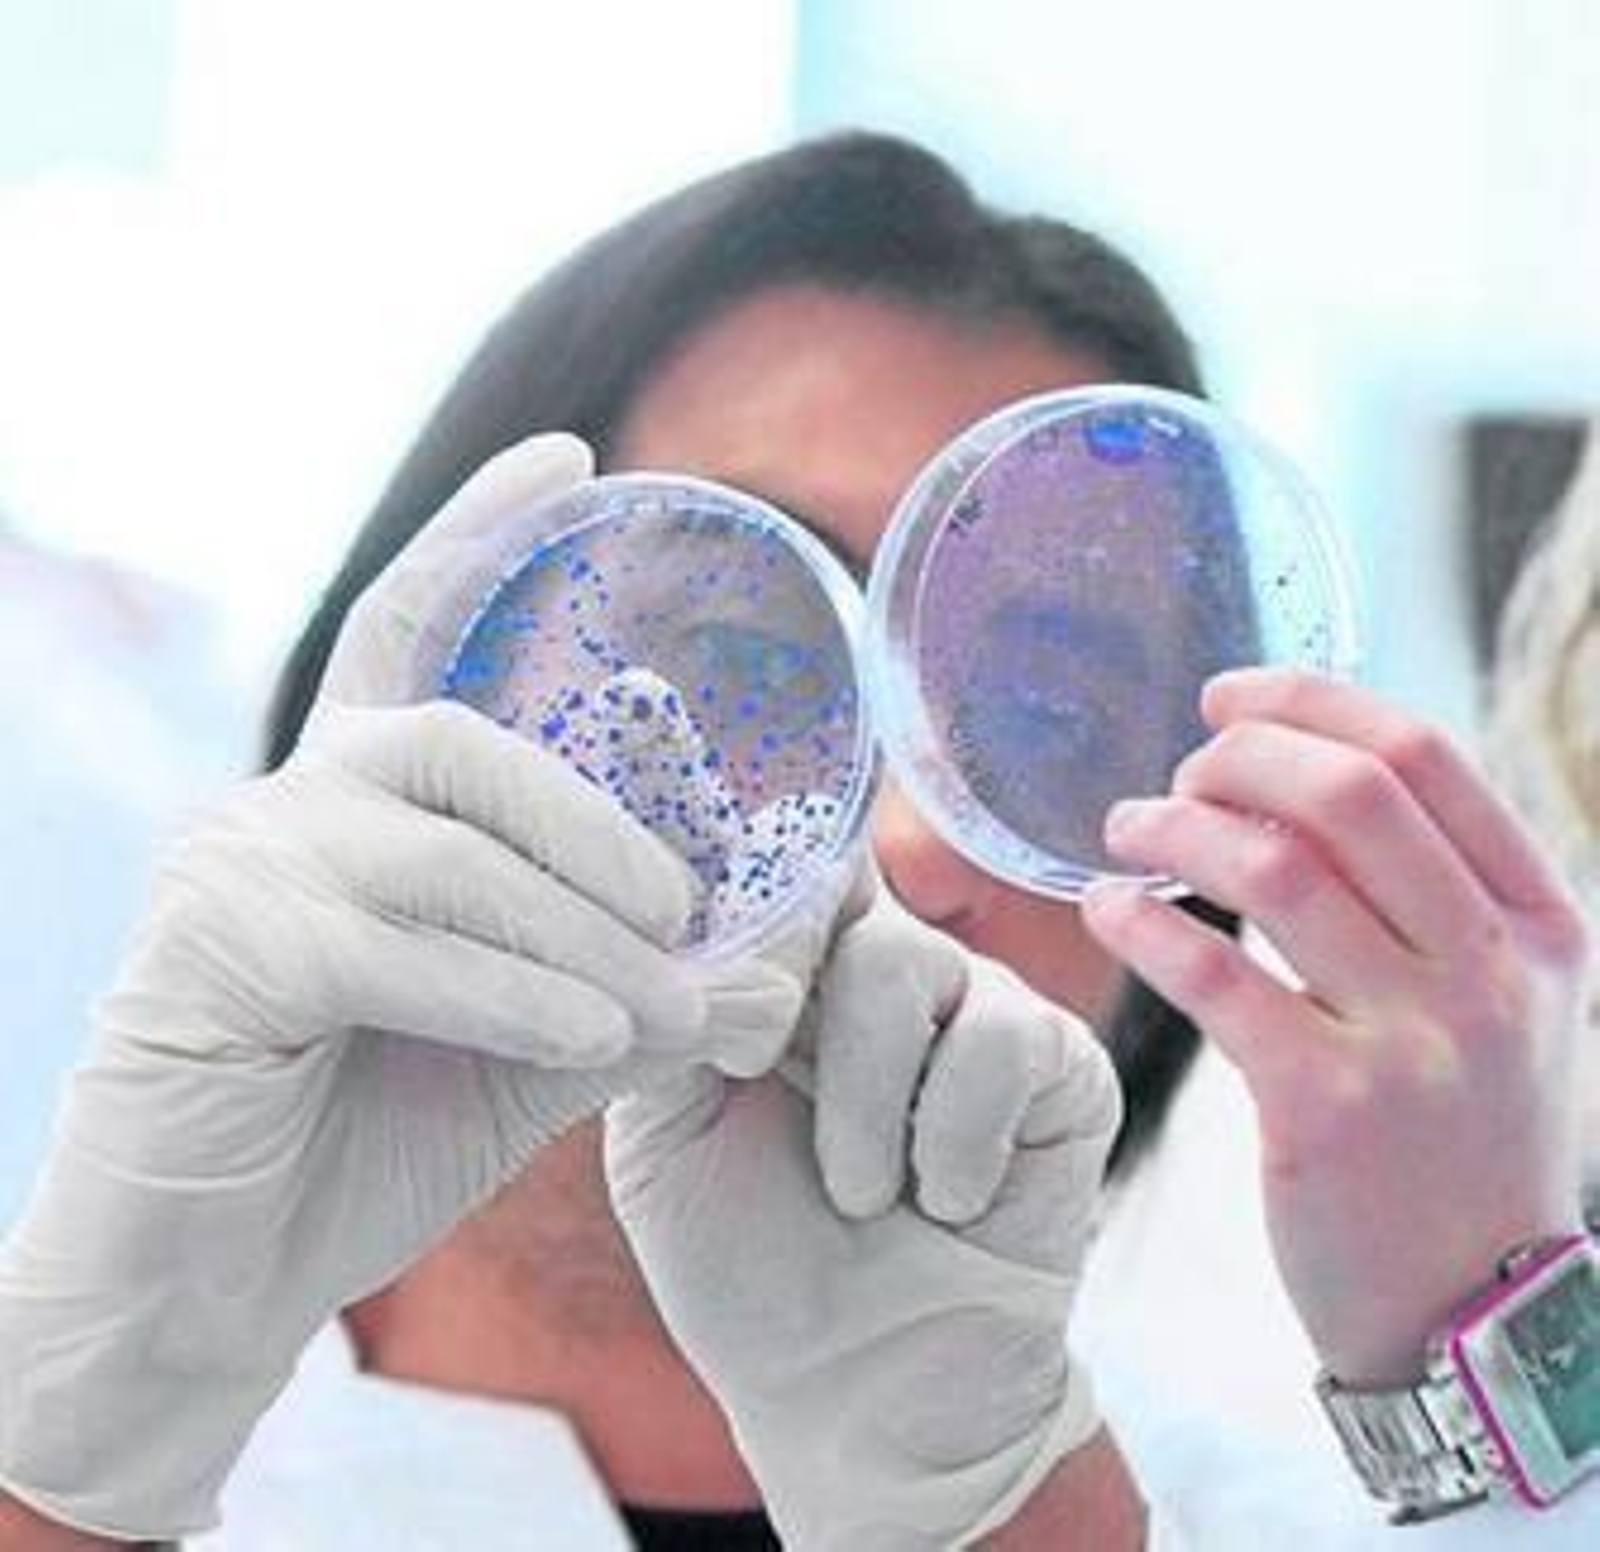

Granada lidera los estudios para averiguar el origen genético del lupus
La Fundación Ramón Areces financiará una investigación del Genyo en el PTS

Un proyecto de investigación andaluz desarrollado en el Centro Genyo, situado en el Parque Tecnológico de la Salud de Granada, será financiado por la Fundación Ramón Areces con 100.000 euros durante tres años para estudiar el componente genético de la enfermedad del lupus.
Se trata de una de las más de 40 ayudas concedidas este año por esta institución que promueve la investigación en España en aquellas disciplinas científicas en fase de desarrollo que requieren de importantes recursos económicos para equipamiento y consecución. Han concurrido 444 proyectos en las áreas de Ciencias de la Vida y de la Materia.
La investigación, titulada Secuenciación Completa del genoma exómico del Lupus Eritematoso Sistémico en familias de casos múltiples de origen europeo: identificación de mutaciones raras y sus consecuencias funcionales, está liderada por la investigadora Marta Alarcón y tiene como fin identificar las mutaciones raras que determinan el componente genético en familias con alta prevalencia de la enfermedad y llegar a comprender los mecanismos que llevan a su desarrollo, según informa en una nota el Gobierno andaluz.
Pese a que el Lupus Eritematoso Sistémico (LES) es una enfermedad crónica autoinmune, existen casos (alrededor de un 10%) en los que el origen es familiar, por lo que al menos dos o tres personas de una misma familia la pueden padecer. El equipo de investigación que desarrolla este proyecto cree que en estos casos existirán alteraciones que son raras en la mayoría de la población. "Tenemos ADN de familias de este tipo y lo que vamos a hacer es utilizar las tecnologías de secuenciación de última generación para leer el ADN de todos sus genes y determinar la presencia de tales mutaciones", explica la doctora Alarcón, quien señala que "en teoría, dichas alteraciones no deben hallarse en individuos sanos y deberán compartirse entre los pacientes de una o varias familias".
Este proyecto ayudará a comprender los mecanismos que llevan al desarrollo del lupus, una patología compleja con una mortalidad alta en mujeres jóvenes, cuya causa es aún desconocida y que se caracteriza por la inflamación y el daño de tejidos, y a mejorar las posibilidades de hallar tratamientos eficientes.
También te puede interesar
Lo último
Contenido ofrecido por Aguasvira
Contenido ofrecido por CEU en Andalucía










